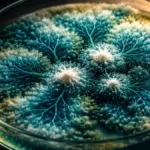
scoperte-scientifiche-casuali-serendipita-storia

Un gruppo di fisici provenienti dall’Università della California a Davis, dal Los Alamos National Laboratory e dal Politecnico federale di Losanna ha presentato un’originale interpretazione della realtà quantistica, mettendo in discussione il pensiero tradizionale nel campo.

Il loro studio, disponibile sul server di prestampa arXiv e ancora in attesa di essere sottoposto a revisione paritaria, offre una nuova prospettiva sulla meccanica quantistica, la quale, come noto, si occupa di descrivere il comportamento degli atomi e delle particelle subatomiche, introducendo il concetto di incertezza fondamentale.
Secondo questa teoria, gli oggetti non manifestano proprietà definite, come velocità e posizione, fino a quando non vengono effettivamente misurati. Invece, esistono come potenziali onde di possibilità, rappresentanti tutti i risultati possibili.
Questa nuova interpretazione si discosta dalle concezioni tradizionali, come quella proposta negli anni ’50 da Hugh Everett, nota come interpretazione dei “molti mondi”, che sostiene l’esistenza di una moltitudine infinita di realtà parallele, o “mondi”, ognuna caratterizzata da un diverso risultato di misura.
Il nuovo studio propone un’ulteriore evoluzione di questa teoria, suggerendo un concetto che incorpora ancora più mondi, indicando che la nostra comprensione attuale della realtà quantistica potrebbe essere limitata poiché si concentra su sottosistemi specifici, come ad esempio la famosa scatola di Schrödinger.
Per superare questo limite concettuale, i ricercatori hanno sviluppato un algoritmo che considera il contesto più ampio dei sistemi quantistici, scoprendo la possibilità di specificare alcune proprietà quantistiche in modo più preciso rispetto a quanto precedentemente ipotizzato. Questo potrebbe ridurre la probabilità che alcune proprietà cruciali rimangano indefinitamente incerte.
Di conseguenza, la concezione tradizionale della celebre tavola descrittiva del gatto di Schrödinger potrebbe risultare incompleta se non si tiene conto del contesto più ampio, che potrebbe includere non solo l’ambiente immediato, ma addirittura galassie distanti.
Uno degli autori dello studio, il fisico Arsalan Adil dell’Università della California, ha spiegato che in teoria non ci sono limiti su come definire i sottosistemi, permettendo di includere una vasta gamma di stati sia vicini che lontani, influenzando radicalmente la concezione della realtà.
Sebbene gli autori riconoscano che l’algoritmo sviluppato non abbia un’immediata rilevanza concettuale, ritengono che possa aprire la strada allo sviluppo di nuove metodologie per lo studio dei sistemi quantistici, con potenziali impatti nel campo dei computer quantistici e di altre tecnologie avanzate.
Scarica la nostra app e ricevi notizie, curiosità, misteri, scoperte e tecnologia direttamente sul tuo smartphone.
Scarica per AndroidMi occupo di fornire agli utenti delle news sempre aggiornate, dal gossip al mondo tech, passando per la cronaca e le notizie di salute. I contenuti sono, in alcuni casi, scritti da più autori contemporaneamente vengono pubblicati su Veb.it a firma della redazione.